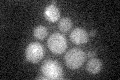
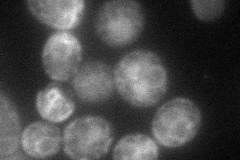
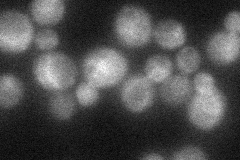
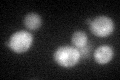
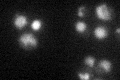

View description
Vacuolar carboxypeptidase Y (proteinase C; CPY), broad-specificity C-terminal exopeptidase involved in non-specific protein degradation in the vacuole; member of the serine carboxypeptidase family
Localization:
Intensity:
Fold change:
Significance:
-
C’ GFP library in SD
cytosol20.51 -
N' NOP1pr-GFP in SD
ER66.6872 -
N' TEF2pr-mCherry in SD

vacuole27.0775 -
N' NATIVEpr-GFP in SD
ER,punctate31.5804 -
N' TEF2pr-VC and Cyto-VN in SD

#N/A0 -
C’ GFP library in SD+DTT
cytosol20.931.02No -
C’ GFP library in SD+H2O2

cytosol22.641.1No -
C’ GFP library in Starvation Media
vacuoleN/AN/AYes -
C’ GFP library on the background of Pup2-DaMP

cytosol -
C’ GFP library on the background of CCT mutant

cytosol22.64271.10349No
